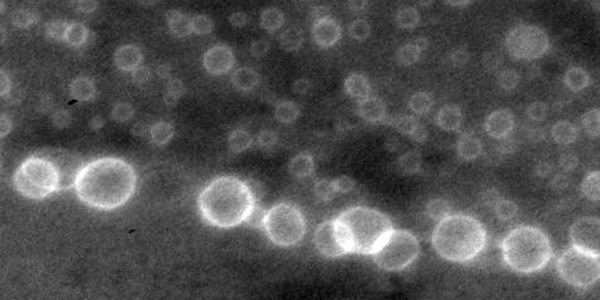

Researchers and Teachers-Researchers
Phd students of PDP team
Post-doc of PDP team
| post-doc |
|---|
| 2023-2024 Qin Qin |
| 2015: Hanna Pazniak |
Research activities
Context
The research activities of the PDP axis concern several issues related to structural defects in materials, whether localized or widespread, and the resulting properties at the macroscopic scale. Whether mechanical (plasticity, brittleness), electrical (conduction, semiconduction), or magnetic, these properties are determined by the fine structures of the defects, their interactions, and their organization. The relevant length scales thus range from the atomic scale (fine structure of defects) to the macroscopic scale (overall behavior) via the mesoscopic scale (microstructure).
Physics of dislocations and plasticity
The research activities grouped together in this operation aim to improve our understanding of dislocations and the elementary mechanisms of plasticity in bulk materials or nanostructures, and the resulting properties at the macroscopic scale. The characterization and modeling of defect properties such as dislocations and grain boundaries are central activities here. The focus is on model materials (semiconductors, oxides, metals) on the one hand, and on systems with more complex structures (MAX phases, multiphase and/or nanocrystalline materials) on the other.
Defects, irradiation, and induced properties
This research project brings together various studies on defects in semiconductors. These defects are mainly created by irradiation or implantation (light ions, noble gases, electrons, etc.). The topics covered are very diverse, ranging from the fundamental study of defects (formation, evolution, etc.) to their possible use in applications (“defect engineering”). The semiconductors studied are mainly Si, SiC, Ge, and GaN.
Tools
Researchers in this area use a variety of tools for characterizing and modeling defects, adapted to these different scales. The non-exhaustive list includes numerical simulations (atomistic calculations, ab initio methods), transmission electron microscopy and atomic force microscopy imaging techniques, detection of localized electronic states in the gap (DLTS), and characterization using X-ray techniques. In addition, a large part of the research activities concerns the study of deformation mechanisms under various thermomechanical stresses, which has led to the development of original deformation techniques, allowing, for example, the use of confinement pressure.
Research programs
Projects led by the team
| program |
|---|
| ANR Blanche "BrIttle to DUctile transition in silicon at Low dimensions, BIDUL" (J. Godet, 2012-2016) |
| ANR Blanche "Materials with Elementary Tailored Architecture for Functional Optimized Response: from Experiments to Simulations, METAFORES" (L. Thilly, 2012-2017) |
| ANR Blanche "Influence de la contrainte appliquée sur la précipitation des hydrures de zirconium, SIZHIP" (L. pizzagalli, 2012-2016) |
| ANR Blanche "Etude fondamentale de la plasticité de matériaux composites recyclables Al/Al-Cu-Fe, FutureAlCo" (A. Joulain, 2013-2017) |
Team involved as a partner
| projets non portés |
|---|
| ANR 'DINACS' Defects in Nanocrystals: Coherent Diffraction Imaging and Simulation (2019-2026) |
| LABEX "INTERACTIFS" (C. Coupeau, 2012-2019) |
| ANR Blanche "Synthèse et caractérisation de monocristaux de phases MAX, MAXICRYST" (S. Dubois, 2013-2017) |